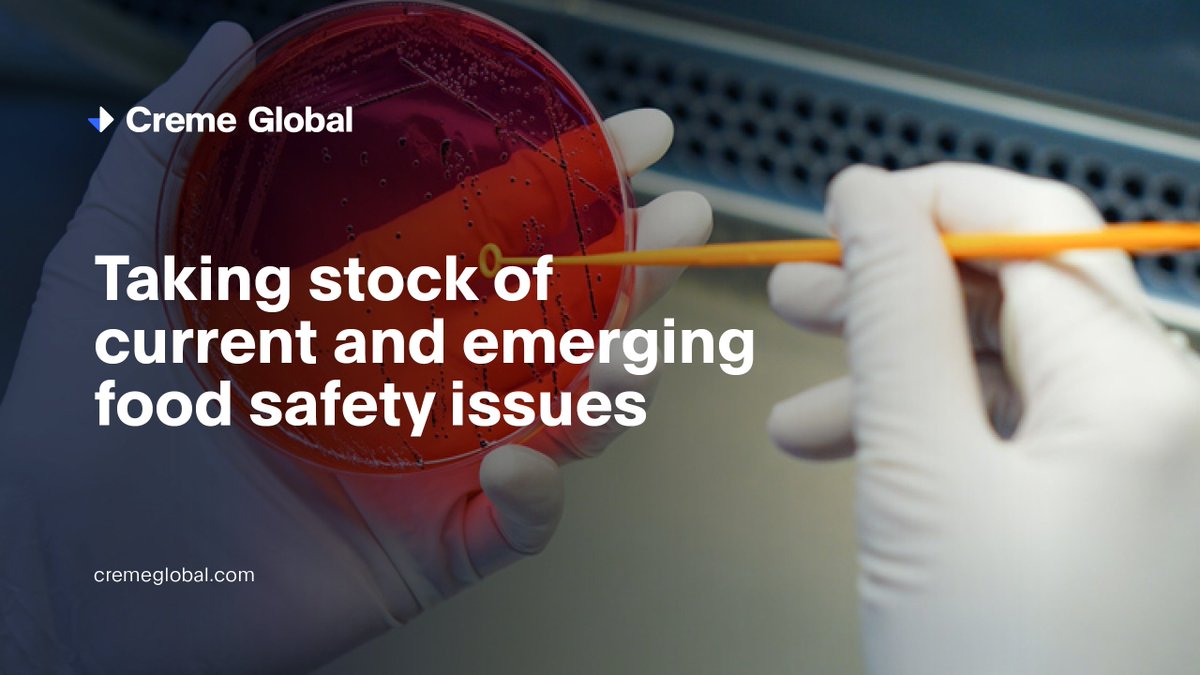
Creme Global tweet media

Sabitlenmiş Tweet

It has been a great journey with Predict over the past five years but we are sorry to announce that Predict Conference will not be running in 2020. A sincere thank you to all of our partners, speakers, attendees, supporters and friends over the years. #predictconf
English